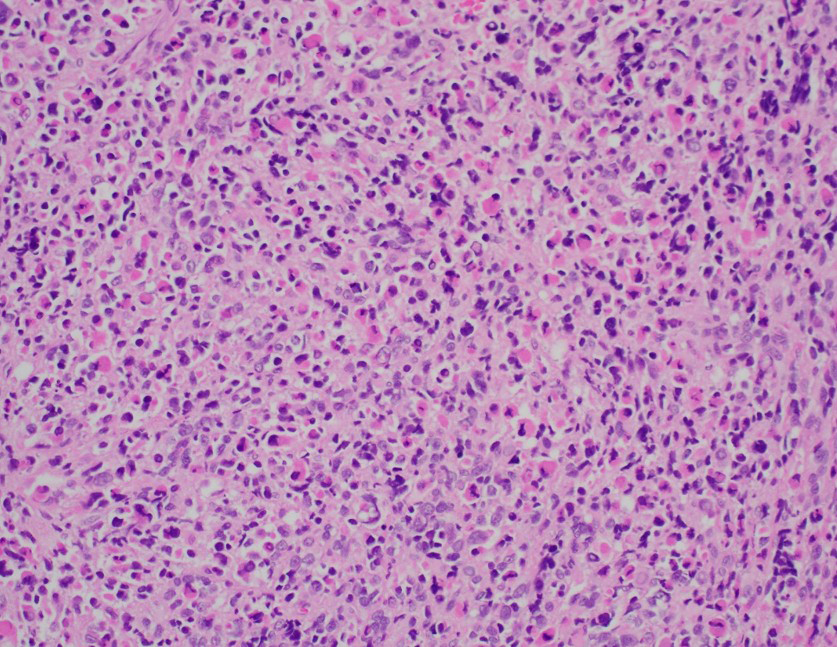
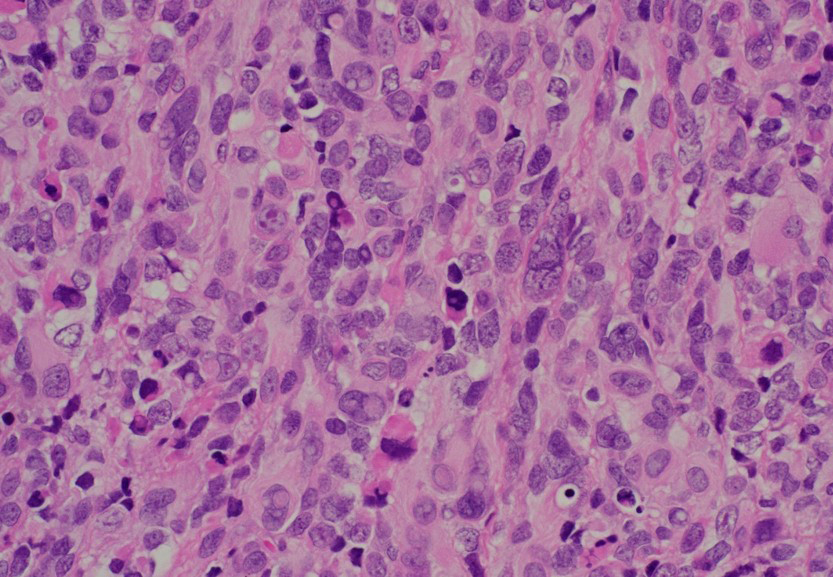

Soft Tissue Lesion of the Thigh in a Young Child
Soft Tissue Lesion of the Thigh in a Young Child
Veronica Ulici, M.D., Ph.D., Roula Katerji, M.D.
Clinical History
A previously healthy 5-year-old boy presented with a one-year history of a slowly enlarging mass in the left thigh. The lesion began as a “wart-sized” nodule and gradually increased to approximately 2.0 cm. Clinically, it appeared as a raised, soft, mildly erythematous nodule with a faint bluish discoloration. It was minimally tender and non-warm.
Given its clinical appearance, the mass was initially suspected to represent a vascular malformation. The mass was surgically resected and revealed a 2.0 × 1.4 × 1.0 cm tan-pink nodule with a glistening, fleshy cut surface and no appreciable necrosis or hemorrhage.
Microscopic Findings
Histologic sections demonstrated a primitive small round blue cell neoplasm arranged in sheets (image 1). The tumor cells were round to polygonal with high nuclear-to-cytoplasmic ratios, vesicular chromatin, prominent nucleoli, and brisk mitotic activity (image 2). Scattered multinucleated tumor cells were identified in addition to cells with eccentrically placed nuclei and abundant eosinophilic cytoplasm (images 3 and 4). Immunohistochemistry showed strong desmin (image 5) and myogenin positivity (image 6) and focal MyoD1 supportive of skeletal muscle differentiation. Stains for cytokeratin, S100, CD45, CD99, and CD34 were negative, excluding epithelial, neural, lymphoid, and vascular neoplasms.
FISH analysis demonstrated a FOXO1 gene rearrangement, supporting the diagnosis.